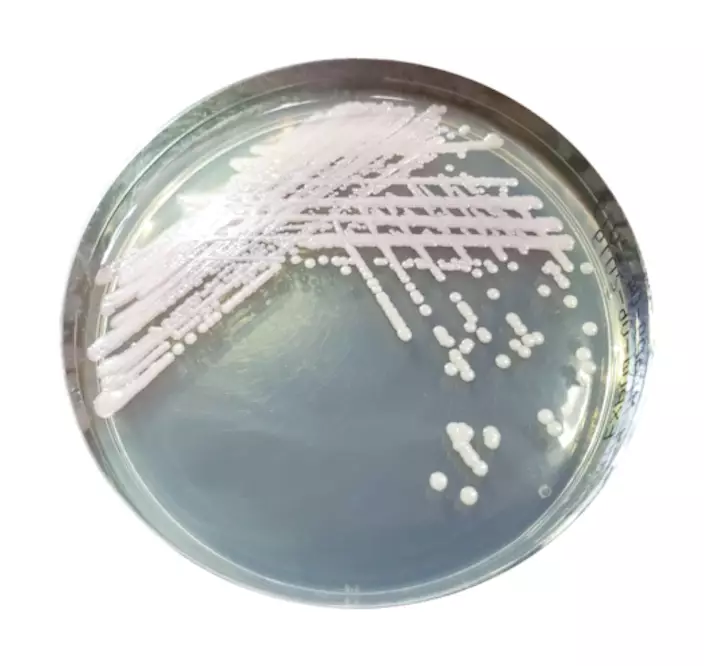

靈實醫院發現耳念珠菌個案組群,涉及5名內科及老人科病房男病人,其中一人死亡。

耳念珠菌。醫管局圖片
醫院發言人表示,病房1名82歲男病人確診帶有耳念珠菌。院方展開追蹤篩查,再發現多4名68歲至94歲男病人帶有耳念珠菌。

靈實醫院。 資料圖片
當中1名病人因自身疾病於11日離世,3名病人現於醫院接受隔離治療,情況穩定。另外1名病人已於9月29日轉送到安老院舍,現時正接受隔離。


社會事
靈實醫院發現耳念珠菌個案組群,涉及5名內科及老人科病房男病人,其中一人死亡。
耳念珠菌。醫管局圖片
醫院發言人表示,病房1名82歲男病人確診帶有耳念珠菌。院方展開追蹤篩查,再發現多4名68歲至94歲男病人帶有耳念珠菌。

靈實醫院。 資料圖片
當中1名病人因自身疾病於11日離世,3名病人現於醫院接受隔離治療,情況穩定。另外1名病人已於9月29日轉送到安老院舍,現時正接受隔離。
醫院管理局將於2026年7月舉行第四場生死教育分享會,主題為「以愛為居 在家安寧」,由靈實醫院紓緩治療服務團隊主講,內容涵蓋晚期病人在家寧養及離世的實際考慮、相關照顧及安排的計劃。
活動將於2026年7月11日(星期六)上午10時至中午12時舉行,地點為九龍亞皆老街147B號醫院管理局大樓閣樓演講廳,設有現場及網上直播兩種參與形式,以廣東話進行,對象為醫院管理局病人及照顧者、義工、職員及公眾人士。有興趣人士可透過指定連結報名,截止日期為2026年6月30日,名額有限,先到先得。查詢可致電2300 7159。

醫管局生死教育分享會7月舉行 探討在家寧養晚期病人